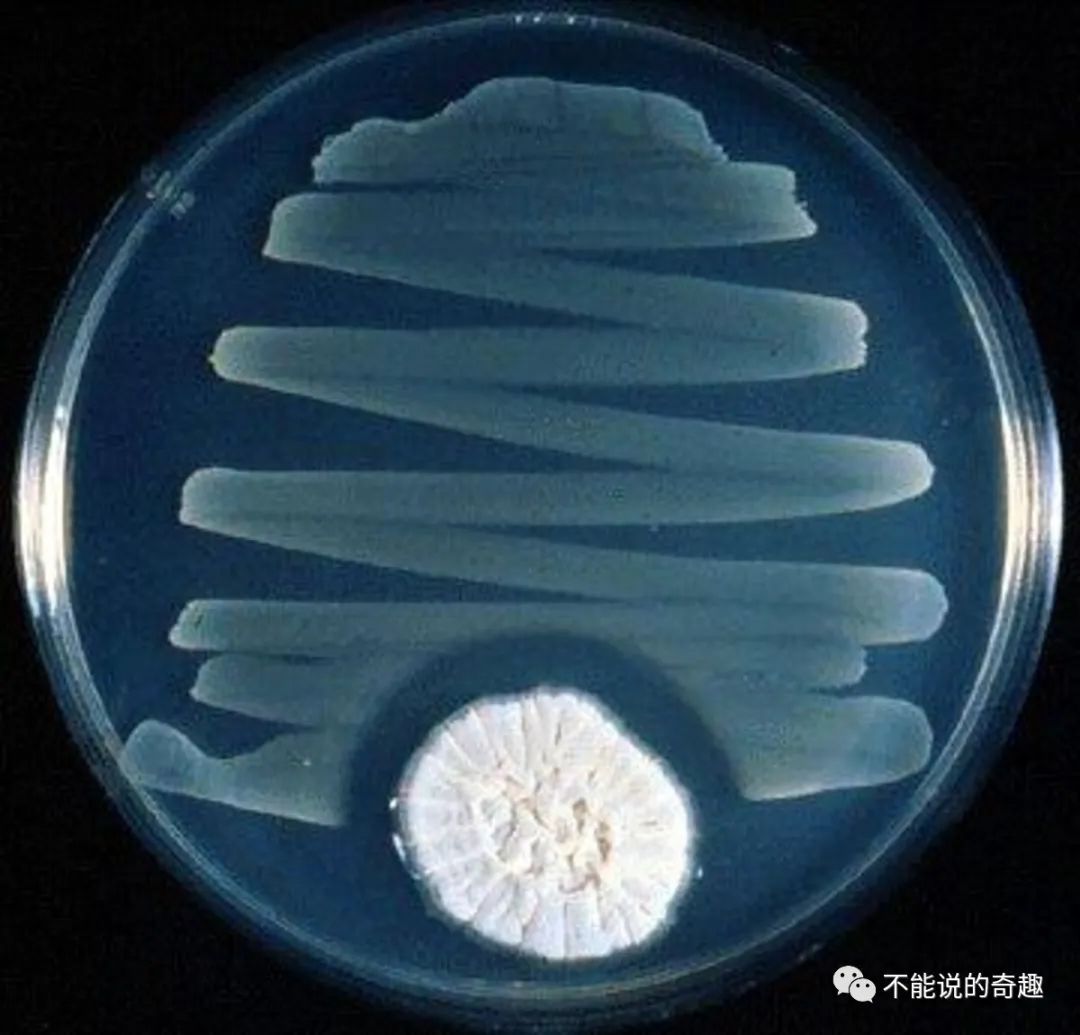
被科学耽搁的亚历山大:发现青霉菌不被重视,微生物作画流传至今

产紫青霉

一种产紫青霉菌db1菌株及其制备和应用
图片尺寸819x838
产紫青霉
图片尺寸358x212
产紫青霉(菌种)
图片尺寸500x450
淡紫拟青霉对根线虫作用不大淡紫拟青霉的作用
图片尺寸800x320
详细聊一聊淡紫拟青霉菌与根结线虫
图片尺寸500x375
淡紫拟青霉(又名:淡紫紫孢菌),是一种优异的生防真菌,用于防 - 抖音
图片尺寸1280x2780
青霉菌的培养基分为那几大类
图片尺寸300x225
青霉菌.40倍镜.
图片尺寸1680x1980
citrinum)展青霉(pen.
图片尺寸494x497
产黄青霉
图片尺寸165x220
霉菌图谱-产黄青霉菌penicillium chrysogenum
图片尺寸3024x4032
活菌50亿淡紫拟青霉紫孢菌厂家直销农作物根结线虫毛囊用1000g袋
图片尺寸300x300
种植如何防治青霉
图片尺寸500x355
竞争性杂菌:青霉
图片尺寸800x600
被科学耽搁的亚历山大:发现青霉菌不被重视,微生物作画流传至今
图片尺寸1080x1035
霉菌图谱-产黄青霉菌penicillium chrysogenum
图片尺寸3024x4032
霉菌图谱-产黄青霉菌penicillium chrysogenum
图片尺寸3024x4032
实验室状态下的淡紫拟青霉菌落
图片尺寸600x397
我们的童年阴影 却在战场上挽救了千万生命|青霉素|细菌|耐药菌_网易
图片尺寸640x615
霉菌图谱-产黄青霉菌penicillium chrysogenum
图片尺寸3024x4032